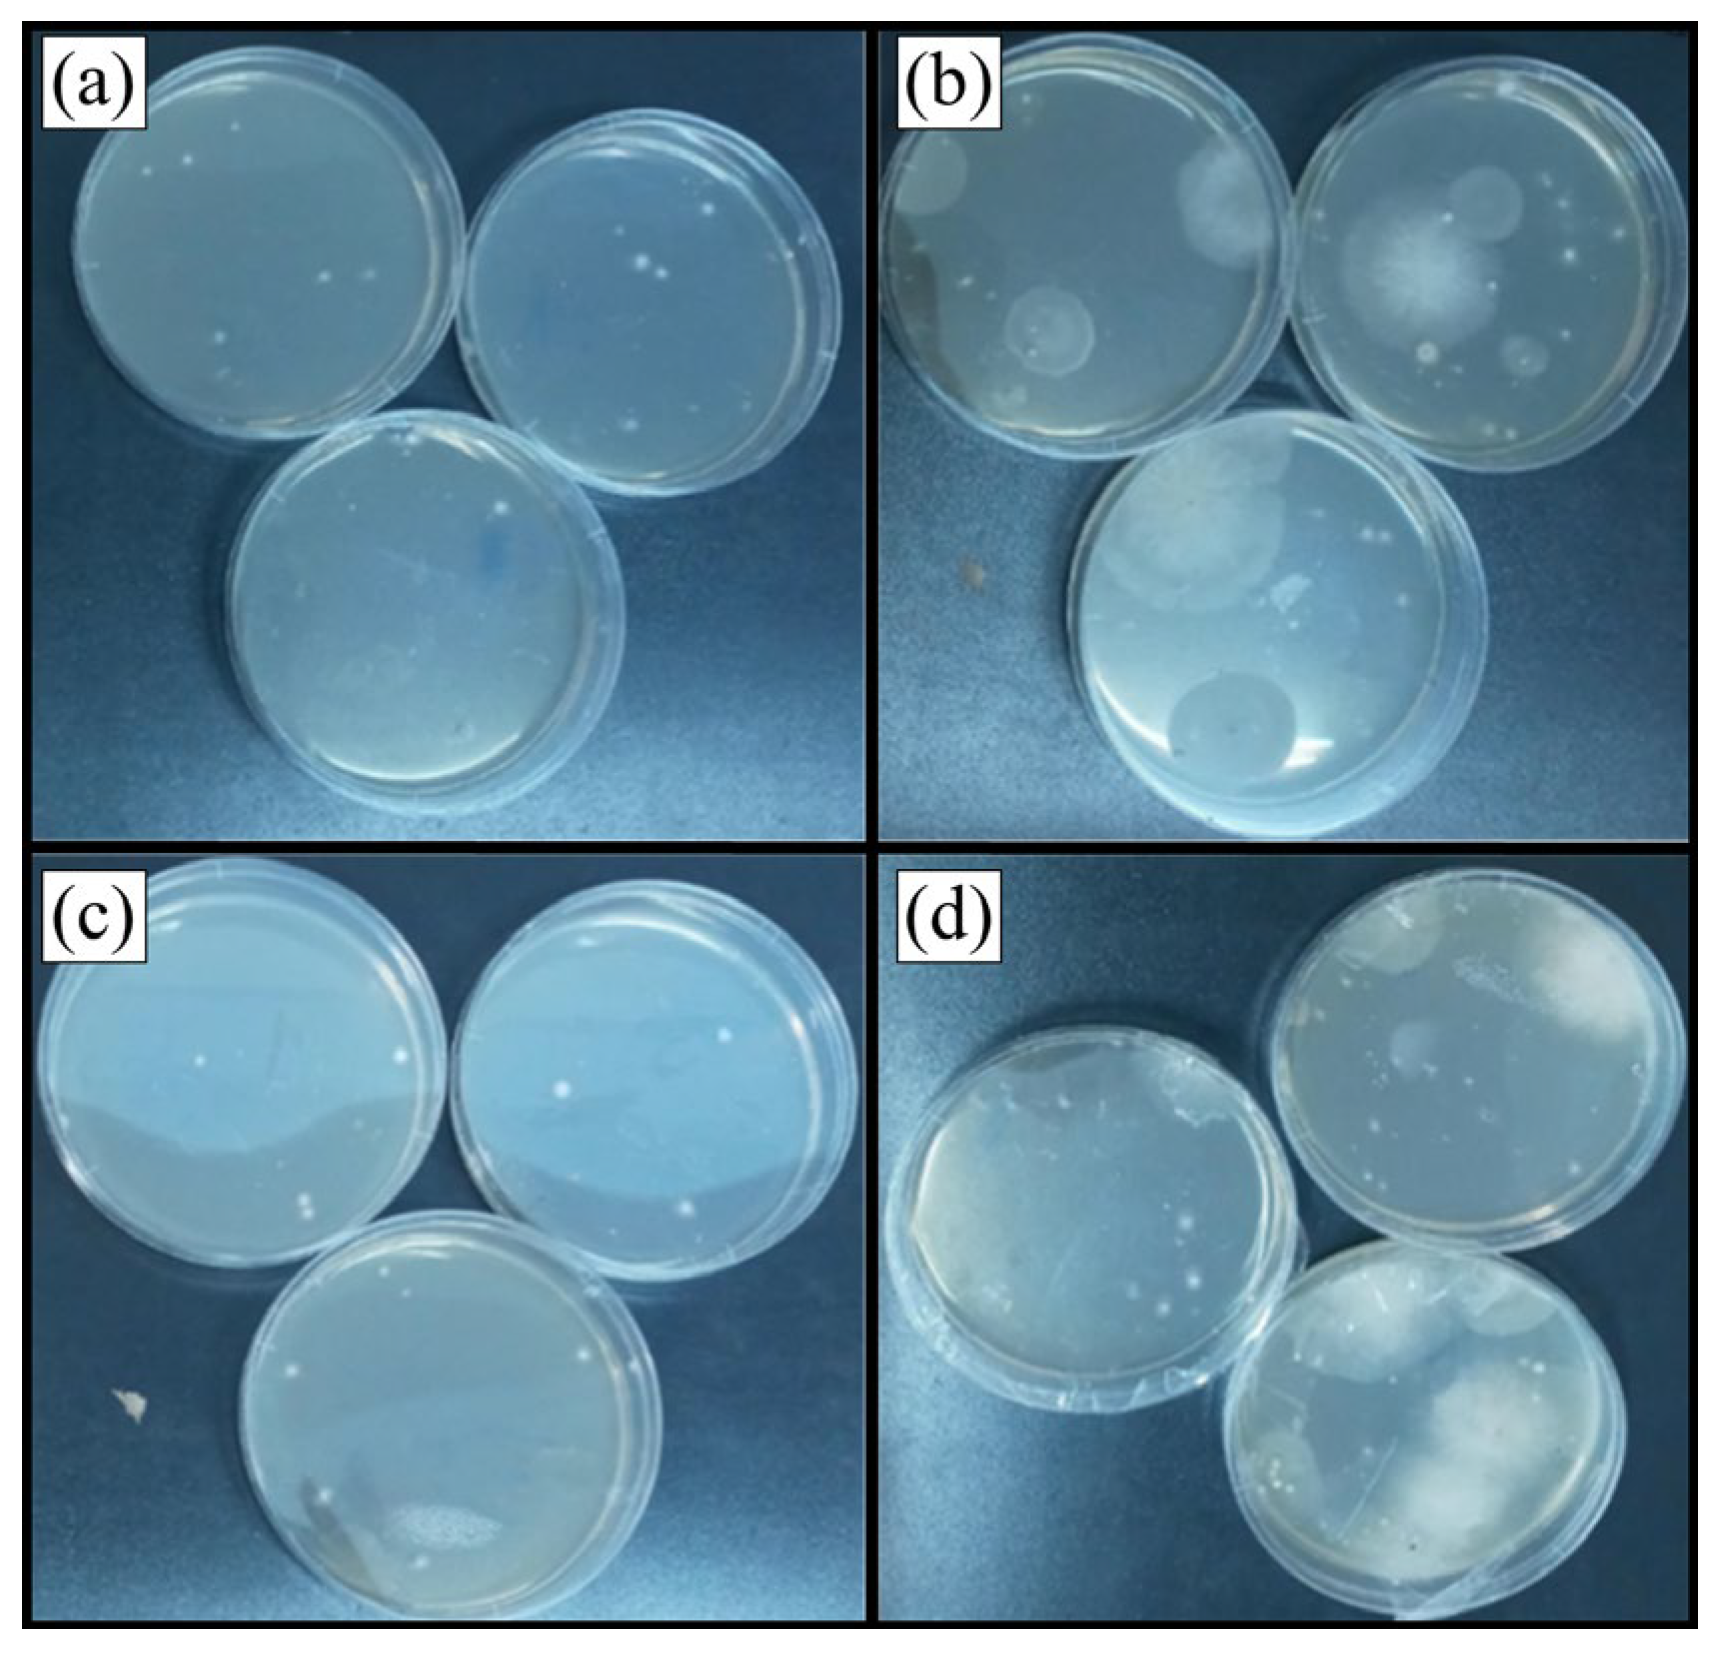
Applsci 14 08136 g010 Applsci 14 08136 g010

Investigating the Role of Microclimate and Microorganisms in the Deterioration of Stone Heritage: The Case of Rupestrian Church from Jac, Romania
Abstract
1. Introduction
2. Materials and Methods
2.1. The Determination of Mineralogical Composition
2.2. The Determination of the Microclimate Characteristics
2.3. The Determination of the Fungal Contamination
3. Results and Discussion
3.1. The Determination of Mineralogical Composition



3.2. The Determination of the Microclimate Characteristics
3.3. The Determination of the Fungal Contamination
4. Conclusions
Author Contributions
Funding
Institutional Review Board Statement
Informed Consent Statement
Data Availability Statement
Acknowledgments
Conflicts of Interest
References
- Gupta, S.P.; Kurmi, M.K. Impact of fungi on historical monument with reference to Mahadev temple Bastar of Chhatisgarh. Int. J. Life Sci. Res. Arch. 2023, 4, 1–5. [Google Scholar] [CrossRef]
- Ilieș, D.C.; Blaga, L.; Hassan, T.H.; Ilieș, A.; Caciora, T.; Grama, V.; Herman, G.V.; Dejeu, P.; Zdringa, M.; Marshall, T.; et al. Indoor Microclimate and Microbiological Risks in Heritage Buildings: A Case Study of the Neologic Sinagogue, Oradea, Romania. Buildings 2023, 13, 2277. [Google Scholar] [CrossRef]
- Ilies, D.C.; Blaga, L.; Ilies, A.; Pereș, A.C.; Caciora, T.; Hassan, T.H.; Hodor, N.; Turza, A.; Taghiyari, H.R.; Barbu-Tudoran, L.; et al. Green Biocidal Nanotechnology Use for Urban Stone-Built Heritage—Case Study from Oradea, Romania. Minerals 2023, 13, 1170. [Google Scholar] [CrossRef]
- Lajçi, D.; Kuqi, B.; Fetahaj, A.; Osmanollaj, S. The values of cultural heritage in the Rugova Region in promoting the development of tourism in Kosovo. GeoJ. Tour. Geosites 2022, 41, 502–508. [Google Scholar] [CrossRef]
- Pyzik, A.; Ciuchcinski, K.; Dziurzynski, M.; Dziewit, L. The Bad and the Good—Microorganisms in Cultural Heritage Environments—An Update on Biodeterioration and Biotreatment Approaches. Materials 2021, 14, 177. [Google Scholar] [CrossRef]
- Chen, X.; Bai, F.; Huang, J.; Lu, Y.; Wu, Y.; Yu, J.; Bai, S. The Organisms on Rock Cultural Heritages: Growth and Weathering. Geoheritage 2021, 13, 56. [Google Scholar] [CrossRef]
- Bungau, C.C.; Bendea, C.; Bungau, T.; Radu, A.-F.; Prada, M.F.; Hanga-Farcas, I.F.; Vesa, C.M. The Relationship between the Parameters That Characterize a Built Living Space and the Health Status of Its Inhabitants. Sustain. Sci. Pract. Policy 2024, 16, 1771. [Google Scholar] [CrossRef]
- Mabrouk, N.; Rashad, Y.; Elmitwalli, H.; Shabana, Y.; Sreenivasaprasad, P.; Elsayed, Y. Assessment of Some Green Fungicides against Fungi Isolated from Different Heritage Sites and Museums in Egypt. Sci. Cult. 2023, 9, 101–112. [Google Scholar]
- Elsayed, Y.; El-Kadi, S.; El-Rian, M.; Mabrouk, N. The Efficiency of Microbial Culture Extracts as Green Antimicrobial Products against Some Microorganisms Colonizing the Historic Oil Paintings. Sci. Cult. 2023, 9, 127–143. [Google Scholar]
- Scheerer, S.; Ortega-Morales, O.; Gaylarde, C. Chapter 5 Microbial Deterioration of Stone Monuments—An Updated Overview. In Advances in Applied Microbiology; Academic Press: Cambridge, MA, USA, 2009; Volume 66, pp. 97–139. [Google Scholar]
- Sterflinger, K. Fungi: Their role in deterioration of cultural heritage. Fungal Biol. Rev. 2010, 24, 47–55. [Google Scholar] [CrossRef]
- Suihko, M.-L.; Alakomi, H.-L.; Gorbushina, A.; Fortune, I.; Marquardt, J.; Saarela, M. Characterization of Aerobic Bacterial and Fungal Microbiota on Surfaces of Historic Scottish Monuments. Syst. Appl. Microbiol. 2007, 30, 494–508. [Google Scholar] [CrossRef] [PubMed]
- Gadd, G.M.; Raven, J.A. Geomicrobiology of Eukaryotic Microorganisms. Geomicrobiol. J. 2010, 27, 491–519. [Google Scholar] [CrossRef]
- Suchý, V.; Borecká, L.; Pachnerová Brabcová, K.; Havelcová, M.; Svetlik, I.; Machovič, V.; Lapčák, L.; Ovšonková, Z.A. Microbial Signatures from Speleothems: A Petrographic and Scanning Electron Microscopy Study of Coralloids from the Koněprusy Caves (the Bohemian Karst, Czech Republic). Sedimentology 2021, 68, 1198–1226. [Google Scholar] [CrossRef]
- Wang, Y.; Zhang, H.; Liu, X.; Liu, X.; Song, W. Fungal Communities in the Biofilms Colonizing the Basalt Sculptures of the Leizhou Stone Dogs and Assessment of a Conservation Measure. Herit. Sci. 2021, 9, 36. [Google Scholar] [CrossRef]
- Lazo, D.E.; Dyer, L.G.; Alorro, R.D. Silicate, Phosphate and Carbonate Mineral Dissolution Behaviour in the Presence of Organic Acids: A Review. Miner. Eng. 2017, 100, 115–123. [Google Scholar] [CrossRef]
- Gerrits, R.; Pokharel, R.; Breitenbach, R.; Radnik, J.; Feldmann, I.; Schuessler, J.A.; von Blanckenburg, F.; Gorbushina, A.A.; Schott, J. How the rock-inhabiting fungus K. petricola A95 enhances olivine dissolution through attachment. Geochim Cosmochim Acta 2020, 282, 76–97. [Google Scholar] [CrossRef]
- Gadd, G.M.; Fomina, M.; Pinzari, F. Fungal Biodeterioration and Preservation of Cultural Heritage, Artwork, and Historical Artifacts: Extremophily and Adaptation. Microbiol. Mol. Biol. Rev. 2024, 88, e0020022. [Google Scholar] [CrossRef]
- Domínguez-Villar, D.; Lojen, S.; Krklec, K.; Baker, A.; Fairchild, I.J. Is Global Warming Affecting Cave Temperatures? Experimental and Model Data from a Paradigmatic Case Study. Clim. Dyn. 2015, 45, 569–581. [Google Scholar] [CrossRef]
- Del Mondo, A.; Hay Mele, B.; Petraretti, M.; Zarrelli, A.; Pollio, A.; De Natale, A. Alternaria Tenuissima, a Biodeteriogenic Filamentous Fungus from Ancient Oplontis Ruins, Rapidly Penetrates Tuff Stone in an In Vitro Colonization Test. Int. Biodeterior. Biodegrad. 2022, 173, 105451. [Google Scholar] [CrossRef]
- Saleh, I.; Hady, M.A.; Moussa, A.; Hefni, Y.; El-Latif, M.L.A. Experimental study for the consolidation and protection of sandstone petroglyphs at Sarabit el Khader (Sinai, Egypt). Sci. Cult. 2018, 5, 43–48. [Google Scholar]
- El-Badry, A.E.-H.A.; Ali, F.A.; Ismail, B.M. Assessment of the aging treatments of sandstone greywacke rock art (wadi hammamat) by petrography, SEM, XRD, EDX. Sci. Cult. 2023, 5, 37–48. [Google Scholar]
- El-Sayed, S.S.M.; Maky, A.R.Y. Archaeometric Investigation to Evaluate Acrylic, Silicon Materials and Nano-Additives as Consolidation Material to Sandstone Monuments of the Sphinxes Avenue (Luxor, Egypt). Sci. Cult. 2021, 8, 51–62. [Google Scholar]
- McNamara, C.; Mitchell, R. Microbial deterioration of historic stone. Front. Ecol. Env. 2005, 3, 445–451. [Google Scholar] [CrossRef]
- Moncmanová, A. Environmental Deterioration of Materials; WIT Press: Southampton, UK, 2007; ISBN 9781845640323. [Google Scholar]
- Sterflinger, K.; Piñar, G. Microbial Deterioration of Cultural Heritage and Works of Art—Tilting at Windmills? Appl. Microbiol. Biotechnol. 2013, 97, 9637–9646. [Google Scholar] [CrossRef] [PubMed]
- Li, T.; Hu, Y.; Zhang, B.; Yang, X. Role of Fungi in the Formation of Patinas on Feilaifeng Limestone, China. Microb. Ecol. 2018, 76, 352–361. [Google Scholar] [CrossRef] [PubMed]
- Ma, Y.; Zhang, H.; Du, Y.; Tian, T.; Xiang, T.; Liu, X.; Wu, F.; An, L.; Wang, W.; Gu, J.-D.; et al. The Community Distribution of Bacteria and Fungi on Ancient Wall Paintings of the Mogao Grottoes. Sci. Rep. 2015, 5, 7752. [Google Scholar] [CrossRef]
- Nugari, M.P.; Pietrini, A.M.; Caneva, G.; Imperi, F.; Visca, P. Biodeterioration of Mural Paintings in a Rocky Habitat: The Crypt of the Original Sin (Matera, Italy). Int. Biodeterior. Biodegrad. 2009, 63, 705–711. [Google Scholar] [CrossRef]
- Favero-Longo, S.E.; Gazzano, C.; Girlanda, M.; Castelli, D.; Tretiach, M.; Baiocchi, C.; Piervittori, R. Physical and chemical deterioration of silicate and carbonate rocks by meristematic microcolonial fungi and endolithic lichens (Chaetothyriomycetidae). Geomicrobiol J. 2011, 28, 732–744. [Google Scholar] [CrossRef]
- Tonon, C.; Breitenbach, R.; Voigt, O.; Turci, F.; Gorbushina, A.A.; Favero-Longo, S.E. Hyphal Morphology and Substrate Porosity-rather than Melanization-Drive Penetration of Black Fungi into Carbonate Substrates. J. Cult. Herit. 2021, 48, 244–253. [Google Scholar] [CrossRef]
- Kim, J.S.; Cho, Y.; Seo, C.W.; Park, K.H.; Yoo, S.; Lee, J.W.; Kim, S.H.; Lee, W.; Lim, Y.W. Fungal Catastrophe of a Specimen Room: Just One Week Is Enough to Eradicate Traces of Thousands of Animals. J. Microbiol. 2023, 61, 189–197. [Google Scholar] [CrossRef]
- Omebeyinje, M.H.; Adeluyi, A.; Mitra, C.; Chakraborty, P.; Gandee, G.M.; Patel, N.; Verghese, B.; Farrance, C.E.; Hull, M.; Basu, P.; et al. Increased Prevalence of Indoor Aspergillus and Penicillium Species Is Associated with Indoor Flooding and Coastal Proximity: A Case Study of 28 Moldy Buildings. Environ. Sci. Process. Impacts 2021, 23, 1681–1687. [Google Scholar] [CrossRef] [PubMed]
- Salvadori, O.; Municchia, A.C. The role of fungi and lichens in the biodeterioration of stone monuments. Open Conf Proceed J. 2016, 7, 39–54. [Google Scholar] [CrossRef]
- Seaward, M.R.D.; Edwards, H.G.M. Biological Origin of Major Chemical Disturbances on Ecclesiastical Architecture Studied by Fourier Transform Raman Spectroscopy. J. Raman Spectrosc. 1997, 28, 691–696. [Google Scholar] [CrossRef]
- Lisci, M.; Monte, M.; Pacini, E. Lichens and Higher Plants on Stone: A Review. Int. Biodeterior. Biodegrad. 2003, 51, 1–17. [Google Scholar] [CrossRef]
- Keshari, N.; Das, S.K.; Adhikary, S.P. Microbial Deterioration of Heritage Monuments in Santiniketan, West Bengal, India. Curr. Sci. 2019, 116, 709–711. [Google Scholar]
- Mang, S.M.; Scrano, L.; Camele, I. Preliminary Studies on Fungal Contamination of Two Rupestrian Churches from Matera (Southern Italy). Sustainability 2020, 12, 6988. [Google Scholar] [CrossRef]
- Cardellicchio, F.; Bufo, S.A.; Mang, S.M.; Camele, I.; Salvi, A.M.; Scrano, L. The Bio-Patina on a Hypogeum Wall of the Matera-Sassi Rupestrian Church ‘San Pietro Barisano’ before and after Treatment with Glycoalkaloids. Molecules 2022, 28, 330. [Google Scholar] [CrossRef]
- Creaca Town Hall. Pemnita Monului Cave Church. 2017. Available online: https://comunacreaca.ro/biserica-rupestra-pemnita-monului/ (accessed on 21 July 2024).
- List of Historical Monuments 2015, Salaj County. Available online: https://www.cultura.ro/sites/default/files/inline-files/LMI-SJ.pdf (accessed on 21 July 2024).
- National Archaeological Inventory (RAN). Information about the Site, the Cave Church from Jac—Pemnita Monului. Available online: https://ran.cimec.ro/sel.asp?descript=jac-creaca-salaj-biserica-rupestra-de-la-jac-pemnita-monului-cod-sit-ran-140734.07 (accessed on 21 July 2024).
- Atlas, R.M. Handbook of Microbiological Media; CRC Press: Boca Raton, FL, USA, 2010. [Google Scholar]
- Richmond, J.Y.; McKinney, R.W. Biosafety in Microbiological and Biomedical Laboratories; US Government Printing Office: Washington, DC, USA, 2009.
- Delegou, E.; Karapiperis, C.; Hilioti, Z.; Chasapi, A.; Valasiadis, D.; Alexandridou, A.; Rihani, V.; Kroustalaki, M.; Bris, T.; Ouzounis, C.; et al. Metagenomics of the built cultural heritage: Microbiota characterization of the building materials of the holy aedicule of the holy sepulchre in Jerusalem. Scient. Cult. 2022, 8, 59–83. [Google Scholar]
- Dott, R.H. Wacke, Graywacke and Matrix; What Approach to Immature Sandstone Classification? J. Sediment. Res. 1964, 34, 625–632. [Google Scholar] [CrossRef]
- Folk, R.L. Petrology of Sedimentary Rocks; Hemphill Pub. Co.: Austin, TX, USA, 1980. [Google Scholar]
- Pettijohn, F.J.; Potter, P.E.; Siever, R. Sand and Sandstone; Springer Science & Business Media: Berlin/Heidelberg, Germany, 1987; ISBN 9780387963501. [Google Scholar]
- Buzgar, N.; Apopei, A.I.; Diaconu, V.; Buzatu, A. The Composition and Source of the Raw Material of Two Stone Axes of Late Bronze Age from Neamt County (Romania)—A Raman Study; Analele Stiintifice de Universitatii AI Cuza din Iasi. Sect. 2, Geologie: Iasi, Romania, 2013; Volume 59, pp. 5–22. [Google Scholar]
- Zhang, G.; Gong, C.; Gu, J.; Katayama, Y.; Someya, T.; Gu, J.-D. Biochemical Reactions and Mechanisms Involved in the Biodeterioration of Stone World Cultural Heritage under the Tropical Climate Conditions. Int. Biodeterior. Biodegrad. 2019, 143, 104723. [Google Scholar] [CrossRef]
- Lafuente, B.; Downs, R.T.; Yang, H.; Stone, N. The power of databases: The RRUFF project. In Highlights in Mineralogical Crystallography; Armbruster, T., Danisi, R.M., Eds.; De Gruyter: Berlin, Germany, 2015; pp. 1–30. [Google Scholar] [CrossRef]
- Norby, P. Synchrotron Powder Diffraction Using Imaging Plates: Crystal Structure Determination and Rietveld Refinement. J. Appl. Crystallogr. 1997, 30, 21–30. [Google Scholar] [CrossRef]
- Magdefrau, E.; Hofmann, U. Biotite, H4K2Mg6Al2Si6O24. Z. Kristallogr. 1937, 98, 2–57. [Google Scholar]
- Neder, R.B.; Burghammer, M.; Grasl, T.H.; Schulz, H.; Bram, A.; Fiedler, S. Refinement of the Kaolinite Structure From Single-Crystal Synchrotron Data. Clays Clay Miner. 1999, 47, 487–494. [Google Scholar] [CrossRef]
- Cuzman, O.A.; Tiano, P.; Ventura, S. Biodiversity on Stone Artifacts, Chapters. In The Importance of Biological Interactions in the Study of Biodiversity; Lopez-Pujol, J., Ed.; IntechOpen: Rijeka, Croatia, 2011. [Google Scholar]
- ICOM-CC. Environmental Guidelines ICOM-CC and IIC Declaration. 2014. Available online: https://www.icom-cc.org/en/environmental-guidelines-icom-cc-and-iic-declaration (accessed on 21 July 2024).
- Šebela, S.; Baker, G.; Luke, B. Cave Temperature and Management Implications in Lehman Caves, Great Basin National Park, USA. Geoheritage 2019, 11, 1163–1175. [Google Scholar] [CrossRef]
- Kukuljan, L.; Gabrovšek, F.; Covington, M.D.; Johnston, V.E. CO2 Dynamics and Heterogeneity in a Cave Atmosphere: Role of Ventilation Patterns and Airflow Pathways. Theor. Appl. Climatol. 2021, 146, 91–109. [Google Scholar] [CrossRef]
- Mattey, D.; Atkinson, T.; Barker, J.; Fisher, R.; Latin, J.; Durrell, R.; Ainsworth, M. Carbon dioxide, ground air and carbon cycling in Gibraltar karst. Geochim. Et Cosmochim. Acta 2016, 184, 88–113. [Google Scholar] [CrossRef]
- Bergel, S.; Carlson, P.; Larson, T.; Wood, C.; Johnson, K.; Banner, J.; Breecker, D. Constraining the subsoil carbon source to cave-air CO 2 and speleothem calcite in central Texas. Geochim. Et Cosmochim. Acta 2017, 217, 112–127. [Google Scholar] [CrossRef]
- Liu, J.; Zhang, D.; Zhou, G.; Faivre-vuillin, B.; Deng, Q.; Wang, C. CO2 Enrichment Increases Nutrient Leaching from Model Forest Ecosystems in Subtropical China. Biogeosciences 2008, 5, 1783–1795. [Google Scholar] [CrossRef]
- Tao, C.; Peng, Y.; Zhang, Q.; Zhang, Y.; Gong, B.; Wang, Q.; Wang, W. Diagnosing ozone–NOx–VOC–aerosol Sensitivity and Uncovering Causes of Urban–nonurban Discrepancies in Shandong, China, Using Transformer-Based Estimations. Atmos. Chem. Phys. 2024, 24, 4177–4192. [Google Scholar] [CrossRef]
- Gao, X.; Wang, Y.; Wu, L.; Zheng, F.; Sun, N.; Liu, G.; Liu, Y.; Meng, P.; Sun, L.; Jing, B. The Impact of Anthropogenic VOC Emissions on Atmospheric Pollution: A Case Study of a Typical Industrialized Area in China. Atmosphere 2023, 14, 1586. [Google Scholar] [CrossRef]
- Zerboni, A.; Villa, F.; Wu, Y.-L.; Solomon, T.; Trentini, A.; Rizzi, A.; Cappitelli, F.; Gallinaro, M. The Sustainability of Rock Art: Preservation and Research. Sustain. Sci. Pract. Policy 2022, 14, 6305. [Google Scholar] [CrossRef]
- CCAH. Available online: https://ccaha.org/resources/light-exposure-artifacts-exhibition (accessed on 21 July 2024).
- Pasanen, A.-L.; Kalliokoski, P.; Pasanen, P.; Jantunen, M.J.; Nevalainen, A. Laboratory Studies on the Relationship between Fungal Growth and Atmospheric Temperature and Humidity. Environ. Int. 1991, 17, 225–228. [Google Scholar] [CrossRef]
- Jain, A.; Bhadauria, S.; Kumar, V.; Chauhan, R.S. Biodeterioration of Sandstone under the Influence of Different Humidity Levels in Laboratory Conditions. Build. Environ. 2009, 44, 1276–1284. [Google Scholar] [CrossRef]
- Taniwaki, M.H.; Hocking, A.D.; Pitt, J.I.; Fleet, G.H. Growth and Mycotoxin Production by Food Spoilage Fungi under High Carbon Dioxide and Low Oxygen Atmospheres. Int. J. Food Microbiol. 2009, 132, 100–108. [Google Scholar] [CrossRef] [PubMed]
- Garaga, R.; Avinash, C.K.R.; Kota, S. Seasonal variation of airborne allergenic fungal spores in ambient PM10—A study in Guwahati, the largest city of north-east India. Air Qual. Atmos. Health 2018, 12, 11–20. [Google Scholar] [CrossRef]
- Korpi, A.; Pasanen, A.L.; Pasanen, P. Volatile Compounds Originating from Mixed Microbial Cultures on Building Materials under Various Humidity Conditions. Appl. Environ. Microbiol. 1998, 64, 2914–2919. [Google Scholar] [CrossRef]
- McLaughlin, J.; Knoppel, H.; The ECA (European collaborative action). Indoor Air Quality and Its Impact on Man; European Union: Brussels, Belgium, 1995. [Google Scholar]
- Porca, E.; Jurado, V.; Martin-Sanchez, P.M.; Hermosín, B.; Bastian, F.; Alabouvette, C.; Saiz-Jimenez, C. Aerobiology: An ecological indicator for early detection and control of fungal outbreaks in caves. Ecol. Indic. 2011, 11, 1594–1598. [Google Scholar] [CrossRef]
- Ogórek, R.; Lejman, A.; Matkowski, K. Influence of the external environment on airborne fungi isolated from a cave. Pol. J. Environ. Stud. 2014, 23, 435–440. [Google Scholar]
- Pusz, W.; Król, M.; Zwijacz-Kozica, T. Airborne fungi as indicators of ecosystem disturbance: An example from selected Tatra Mountains caves (Poland). Aerobiologia 2018, 34, 111–118. [Google Scholar] [CrossRef]
- Ogórek, R. Fungal Communities on Rock Surfaces in Demänovská Ice Cave and Demänovská Cave of Liberty (Slovakia). Geomicrobiol. J. 2018, 35, 266–276. [Google Scholar] [CrossRef]
- Stupar, M.; Savković, Ž.; Popović, S.; Simić, G.S.; Grbić, M.L. Speleomycology of Air in Stopića Cave (Serbia). Microb. Ecol. 2023, 86, 2021–2031. [Google Scholar] [CrossRef] [PubMed]
- Ogórek, R.; Pusz, W.; Lejman, A.; Uklańska-Pusz, C. Microclimate effects on number and distribution of fungi in the Włodarz underground complex in the Owl Mountains (Góry Sowie), Poland. J. Cave Karst Stud. 2014, 76, 146–153. [Google Scholar] [CrossRef]
- Mohamed, S.; Eid Ibrahim, S. Characterization and Management of Fungal Deterioration of Ancient Limestone at Different Sites along Egypt. Egypt. J. Microbiol. 2018, 53, 177–191. [Google Scholar] [CrossRef]
- Ahmed, E.A.-E.; Mohamed, R.M. Bacterial Deterioration in the Limestone Minaret of Prince Muhammad and Suggested Treatment Methods, Akhmim, Egypt. Geomaterials 2022, 12, 37–58. [Google Scholar] [CrossRef]
- De la Rosa-García, S.C.; Ortega-Morales, O.; Gaylarde, C.C.; Beltrán-García, M.; Quintana-Owen, P.; Reyes-Estebanez, M. Influence of Fungi in the Weathering of Limestone of Mayan Monuments. Rev. Mex. Mic 2011, 33, 43–51. [Google Scholar]
- Abdel Ghany, T.M.; Omar, A.M.; Elwkeel, F.M.; Al Abboud, M.A.; Alawlaqi, M.M. Fungal Deterioration of Limestone False-Door Monument. Heliyon 2019, 5, e02673. [Google Scholar] [CrossRef]
- Singh, P.K.; Ahalavat, A.K.; Vimala, Y. Jatropha curcas, Pongamia pinnata Plantation with Glycine max as Safe and Potent Green Energy Source. Ann. Plant Sci. 2014, 2, 520–523. [Google Scholar]
- Savković, Ž.; Stupar, M.; Unković, N.; Knežević, A.; Vukojević, J.; Grbić, M.L. Fungal Deterioration of Cultural Heritage Objects. In Biodegradation Technology of Organic and Inorganic Pollutants; IntechOpen: London, UK, 2021. [Google Scholar]
- De Leo, F.; Urzì, C.; de Hoog, G.S. New Meristematic Fungus, Pseudotaeniolina globosa. Antonie Van Leeuwenhoek 2003, 83, 351–360. [Google Scholar] [CrossRef]
- Gorbushina, A.A.; Krumbein, W.E.; Hamman, C.H.; Panina, L.; Soukharjevski, S.; Wollenzien, U. Role of Black Fungi in Color Change and Biodeterioration of Antique Marbles. Geomicrobiol. J. 1993, 11, 205–221. [Google Scholar] [CrossRef]
- Wollenzien, U.; de Hoog, G.S.; Krumbein, W.E.; Urzí, C. On the Isolation of Microcolonial Fungi Occurring on and in Marble and Other Calcareous Rocks. Sci. Total Environ. 1995, 167, 287–294. [Google Scholar] [CrossRef]
- Dornieden, T.; Gorbushina, A.A.; Krumbein, W.E. Physical and Chemical Interactions of Sub-aerial Biofilms with Objects of Art. In Of Microbes and Art: The Role of Microbial Communities in the Degradation and Protection of Cultural Heritage; Ciferri, O., Tiano, P., Mastromei, G., Eds.; Springer: Boston, MA, USA, 2000; pp. 105–119. [Google Scholar]
- Warscheid, T.; Braams, J. Biodeterioration of Stone: A Review. Int. Biodeterior. Biodegrad. 2000, 46, 343–368. [Google Scholar] [CrossRef]
- Berner, M.; Wanner, G.; Lubitz, W. A Comparative Study of the Fungal Flora Present in Medieval Wall Paintings in the Chapel of the Castle Herberstein and in the Parish Church of St Georgen in Styria, Austria. Int. Biodeterior. Biodegrad. 1997, 40, 53–61. [Google Scholar] [CrossRef]
- Romero, S.M.; Giudicessi, S.L.; Vitale, R.G. Is the Fungus Aspergillus a Threat to Cultural Heritage? J. Cult. Herit. 2021, 51, 107–124. [Google Scholar] [CrossRef]

| Air Sample | Number of Fungal CFU/m3 of Air | Degree of Contamination |
|---|---|---|
| AS1 | 892 | High |
| AS2 | 580 | High |
| AS3 | 367 | Medium |
| AS4 | 1102 | High |
Disclaimer/Publisher’s Note: The statements, opinions and data contained in all publications are solely those of the individual author(s) and contributor(s) and not of MDPI and/or the editor(s). MDPI and/or the editor(s) disclaim responsibility for any injury to people or property resulting from any ideas, methods, instructions or products referred to in the content. |
© 2024 by the authors. Licensee MDPI, Basel, Switzerland. This article is an open access article distributed under the terms and conditions of the Creative Commons Attribution (CC BY) license (https://creativecommons.org/licenses/by/4.0/).
Share and Cite
Ilieș, D.C.; Apopei, A.-I.; Mircea, C.; Ilieș, A.; Caciora, T.; Zharas, B.; Barbu-Tudoran, L.; Hodor, N.; Turza, A.; Pereș, A.C.; et al. Investigating the Role of Microclimate and Microorganisms in the Deterioration of Stone Heritage: The Case of Rupestrian Church from Jac, Romania. Appl. Sci. 2024, 14, 8136. https://doi.org/10.3390/app14188136
Ilieș DC, Apopei A-I, Mircea C, Ilieș A, Caciora T, Zharas B, Barbu-Tudoran L, Hodor N, Turza A, Pereș AC, et al. Investigating the Role of Microclimate and Microorganisms in the Deterioration of Stone Heritage: The Case of Rupestrian Church from Jac, Romania. Applied Sciences. 2024; 14(18):8136. https://doi.org/10.3390/app14188136
Chicago/Turabian StyleIlieș, Dorina Camelia, Andrei-Ionuț Apopei, Cristina Mircea, Alexandru Ilieș, Tudor Caciora, Berdenov Zharas, Lucian Barbu-Tudoran, Nicolaie Hodor, Alexandru Turza, Ana Cornelia Pereș, and et al. 2024. "Investigating the Role of Microclimate and Microorganisms in the Deterioration of Stone Heritage: The Case of Rupestrian Church from Jac, Romania" Applied Sciences 14, no. 18: 8136. https://doi.org/10.3390/app14188136
APA StyleIlieș, D. C., Apopei, A.-I., Mircea, C., Ilieș, A., Caciora, T., Zharas, B., Barbu-Tudoran, L., Hodor, N., Turza, A., Pereș, A. C., Hassan, T. H., Safarov, B., & Noje, I.-C. (2024). Investigating the Role of Microclimate and Microorganisms in the Deterioration of Stone Heritage: The Case of Rupestrian Church from Jac, Romania. Applied Sciences, 14(18), 8136. https://doi.org/10.3390/app14188136

